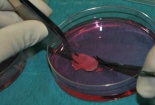
Em bé đầu tiên sinh từ mô trứng đông lạnh gây chấn động khoa học

Công nghệ
Ứng dụng

Nghiên cứu ra băng cứu thương thông minh có thể tiêu diệt siêu vi khuẩn
(VietQ.vn) - Các nhà khoa học tại Trung Quốc đã phát triển một loại băng cứu thương thông minh có thể tự phát hiện và điều trị các loại bệnh nhiễm trùng khác nhau do vi khuẩn gây ra.
-
Em bé đầu tiên sinh từ mô trứng đông lạnh gây chấn động khoa học
Tàu tên lửa Molniya Việt Nam đang sở hữu ‘đáng gờm’ như thế nào?
Uy lực bí ẩn chiến hạm Đinh Tiên Hoàng của Hải quân Việt Nam
Hi vọng hồi sinh khủng long từ hóa thạch 75 triệu năm trước
Nhật Bản tư vấn Việt Nam về việc chọn lò phản ứng hạt nhân
Cách làm mát phòng trọ, ký túc xá, chống nóng ngày hè
Khai quật ngôi mộ cổ 2.000 năm tuổi của 'nàng công chúa ngủ trong rừng'
-

Tiềm năng phát triển dược liệu thành một ngành kinh tế
-

Ứng dụng công nghệ số trong lĩnh vực phòng cháy chữa cháy và cứu nạn cứu hộ
Tin mới Ứng dụng 24h

'Lộ bí ẩn' công nghệ xây dựng hạ tầng giao thông của người Hàn
(VietQ.vn) - Những công nghệ làm cầu đường cực khủng của Hàn Quốc đã được chia sẻ tới các chuyên gia của Việt Nam tại Hội thảo "Công nghệ mới ứng dụng cho xây dựng hạ tầng giao thông".

'Xe tăng bay' Su-34 Nga gây bất ngờ với khoang lái tiện nghi
(VietQ.vn) - Máy bay chiến đấu Su-34 không chỉ có khả năng sử dụng tất cả các loại vũ khí chính xác cao hiện có của Không quân Nga, mà còn sở hữu hệ thống khoang lái rất tiện nghi, hiện đại.

Sinh vật lạ trị giá bạc triệu được nhiều đại gia Việt 'săn đón'
(VietQ.vn) - Trong thế giới thiên nhiên kỳ thú, có rất nhiều sinh vật lạ mang hình thù kỳ dị, độc đáo, bắt mắt, như: cua ma cà rồng, rồng đất, thỏ sư tử,... Chúng thu hút được sự quan tâm, hứng thú của rất nhiều "đại gia" Việt .

Giải mã xác ướp bí ẩn trên đỉnh núi băng cao nhất ở Mexico
(VietQ.vn) - Một nhóm leo núi đã phát hiện xác ướp một người đàn ông chừng 25 tuổi trên đỉnh núi băng Pico de Orizaba, ngọn núi cao nhất Mexico. Giới khoa học hiện đang làm rõ lai lịch của xác ướp bí ẩn trên.

Tiêm kích Su-35: Chiến đấu cơ 'đáng gờm' trong mặt trận trên không
(VietQ.vn) - Tiêm kích Su-35 của Nga được cho là vượt trội hơn hẳn so với các máy bay thế hệ thứ 4 hiện nay của phương Tây. Loại vũ khí quân sự này nhận được sự quan tâm từ nhiều cường quốc bao gồm Mỹ, Trung Quốc.

Khám phá sức mạnh của 'rồng lửa' Gripen-E Việt Nam muốn mua
(VietQ.vn) - Tiêm kích Jas-39 Gripen-E được trang bị hệ Radar quét mạng pha điện tử chủ động Raven, cảm biến hồng ngoại tiên tiến mới được trang bị thêm. Vũ khí quân sự này đang trở thành chiến đấu cơ thực thụ Việt Nam muốn mua.

Phát hiện xương cổ đại minh chứng quá trình phẫu thuật não nguyên thủy
(VietQ.vn) - Các nhà khảo cổ học đã phát hiện một bộ xương cổ đại tại bán đảo Copacabana thuộc vùng hồ Titicaca, Bolivia. Nghiên cứu cho thấy phẫu thuật não đã được thực hiện từ thời nguyên thủy với kỹ thuật thô sơ.

Nam Định: Xuất hiện cá khủng long quái dị gây xôn xao
(VietQ.vn) - Sinh vật lạ là con cá có thân dài, trơn và có hình dạng giống như một chú khủng long nhỏ do một người dân Nam Định bắt được trong khu sinh thái Núi Ngăm đang gây xôn xao dư luận.

Tình hình phát triển điện hạt nhân trên toàn thế giới
(VietQ.vn) - Năng lượng hạt nhân đang là lựa chọn hàng đầu của nhiều quốc gia trong bối cảnh khủng hoảng năng lượng hóa thạch còn các nguồn năng lượng tái tạo vẫn chưa cho thấy hiệu quả rõ rệt.

Giải pháp chống nóng cho trần nhà, mái nhà đơn giản mà hiệu quả
(VietQ.vn) - Với tình hình Trái Đất ngày càng nóng lên, không khí ngột ngạt, nóng nực, khó chịu, việc chống nóng cho nhà ởlà rất cần thiết. Trong đó, chống nóng cho trần nhà, mái nhà chính là cách làm mát nhà đơn giản, hiệu quả nhất.

Xây dựng kính thiên văn lớn nhất thế giới khám phá mọi bí ẩn vũ trụ
(VietQ.vn) - Giới khoa học ở Chile cùng 11 đối tác quốc tế đang xây dựng chiếc kính thiên văn lớn nhất thế giới trên một ngọn núi ở Las Campanas Observatory, Chile. Dự kiến công trình vĩ đại này sẽ được chính thức sử dụng năm 2024.

Kỹ thuật trồng nấm mèo trong nhà đơn giản, cho năng suất cao nhất
(VietQ.vn) - Nấm mèo là loại nấm ăn được có giá trị bổ dưỡng rất cao, chứa nhiều hoạt chất giúp tăng cường hệ miễn dịch, giải độc và làm giảm sự lão hóa. Kỹ thuật trồng nấm mèo đơn giản nên được người dân ưa chuộng.

Sức mạnh tiềm ẩn của 'quái vật' Kurganets-25 Nga
(VietQ.vn) - Xe chiến đấu bộ binh bọc thép tối tân Kurganets-25 của Nga ngày càng thể hiện sức mạnh tiềm ẩn của mình với những trang bị tháp pháo điều khiển từ xa thế hệ mới tiên tiến nhất.

Khám phá sự thay đổi của não người trong hành trình lên Sao Hỏa
(VietQ.vn) - Mới đây, các nhà khoa học NASA đã có một nghiên cứu mới về những thay đổi lớn của bộ não người khi phải tiếp xúc với các tia vũ trụ trong cuộc hành trình khám phá Sao Hỏa.

Thực hư 2 sinh vật thời tiền sử quý hiếm xuất hiện ở Trung Quốc
(VietQ.vn) - Mới đây, các nhà khoa học đã phát hiện thấy 2 loài sinh vật thời tiền sử gồm cua móng ngựa và tôm cổ tích xuất hiện ở vùng ngoại ô Thiên Bành Trấn, Trung Quốc.

Cách chống nóng cực hiệu quả cho ngôi nhà từ bên ngoài
(VietQ.vn) - Ngăn không cho sức nóng vào trong nhà là cách làm mát nhà tiết kiệm điện hơn hẳn so với sử dụng điều hòa. Bằng việc tạo lối thoát cho không khí hay lắp kính phản quang,... ngôi nhà sẽ trở nên "mát mẻ" hơn nhiều.

Vén màn bí ẩn cơn sốt vàng cách đây 4.500 năm ở Anh
(VietQ.vn) - Mới đây, các nhà khảo cổ học Anh đã phát hiện ra bằng chứng mới về con đường buôn bán tạo tác bằng vàng thời tiền sử cách đây 4.500 năm, nằm giữa vùng Devon, Cornwall (Anh) và Ireland.

Mỹ cấy ghép thành công hộp sọ cho người mắc chứng ung thư hiếm gặp
(VietQ.vn) - Các bác sĩ tại trung tâm Ung thư MD Anderson tại Mỹ đã cấy ghép thành công hộp sọ cho một bệnh nhân ung thư đầu tiên trên thế giới. Ca phẫu thuật đã mang lại một cuộc sống mới với người bệnh.

ADN đời bố mẹ xấu khiến con cái nhiều bệnh tật
(VietQ.vn) - Theo nghiên cứu về di truyền học, khoảng 5% DNA của con người có khả năng chống tái lập trình và có thể mang những lỗi lầm từ đời này vào thế hệ tiếp theo, làm tăng nguy cơ mắc bệnh tâm thần và béo phì.

Xôn xao heo 2 đầu được coi là 'thần hộ mệnh' ở Trung Quốc
(VietQ.vn) - Một người nông dân sinh sống ở phía Tây Nam Trung Quốc cho biết, trong lứa heo 11 con của ông có một chú heo con 2 đầu. Người này nuôi hy vọng rằng con vật lạ kỳ sẽ mang lại nhiều may mắn cho chủ.














